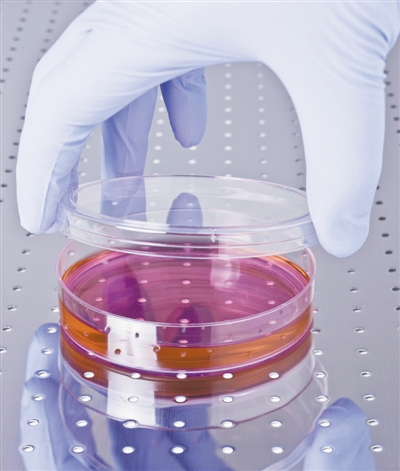
国内批准的干细胞治疗机构,中国干细胞治疗新进展

科技日报实习记者 于紫月
干细胞因其再生能力往往被人们寄予“青春泉”式的魔幻期待,然而,打着干细胞疗法的幌子牟取暴利的事件也频见舆论。
视觉中国
近日,美国对非正规干细胞疗法的治理又一次引发了人们对这种新兴的医疗技术及相关产品的关注。美国食品药品监督管理局(FDA)表示,佛罗里达州一家地方法院判定美国一家干细胞公司旗下诊所违法。该机构宣称来源于脂肪组织的间充质干细胞产品可有效治疗包括帕金森病、视网膜黄斑变性等多种病症,而事实上这一干细胞疗法尚未被证实安全有效。
干细胞难以包治百病
干细胞是一类具有自我复制能力的多潜能细胞。在一定条件下,它可以分化为功能细胞。研究人员利用其分化、增殖的特点,把健康的干细胞移植到患者体内,修复或替换受损细胞或组织,从而达到治愈的目的,这就是人们常说的干细胞疗法。
学界将这颗21世纪初兴起的新星视若瑰宝,使用其他医疗技术无法康复的患者也将希望寄托在它的身上。
尽管某些技术还不成熟,强烈的用户需求和巨大的利益攫取足够让一些尚不具备条件的机构利用干细胞疗法冒险。过去几年里,在全世界许多国家和地区,直接面向消费者但未经批准的干细胞治疗行为在持续增长。
“近年来干细胞疗法乱象频生,主要还是在间充质干细胞的应用方面。这类干细胞可以对免疫相关疾病的治疗有所帮助,然而很多不法机构将之用于应对多种疾病,包装成包治百病的‘灵丹妙药’。”同济大学医学院附属东方医院教授左为在接受科技日报记者采访时表示,间充质干细胞移植目前仅被证明对关节炎、移植物抗宿主病等几种特定疾病有效,并非任何疾病都可以用这种干细胞治疗。间充质干细胞的分化潜能是非常有限的,仅一类干细胞就能包治百病的说法没有科学依据。
在左为看来,来源多、易获取、成本低是不法医疗机构“瞄上”间充质干细胞的主要原因。这类干细胞可以从皮下脂肪或血液中获取。相对于其他干细胞,如造血干细胞、肺干细胞、眼角膜缘干细胞等,间充质干细胞分离的技术手段相对简单、培养扩增条件容易达到,经济成本较低廉。
2016年调查显示,351家美国公司向消费者销售所谓的干细胞疗法,几乎一半的公司在他们的营销材料中提到了间充质干细胞。
当然,还有其他类型的干细胞也被当成“摇钱树”。2013年,意大利卫生部叫停了一种基于骨髓干细胞的治疗手段,原因是没有科学依据且可能非常危险;2018年,“我国民众前往乌克兰接受胚胎干细胞治疗、一针10万元”的新闻引发公众讨论,后有相关专家指出,该医疗机构不合规操作,无法达到健康长寿的期望效果,反而有致癌风险。
在左为看来,干细胞治疗“*市黑**”绝大多数情况下没有任何的生物医学理论作为基础,而且在整个干细胞的制备和临床使用流程中也没有规范的监管。
欧美获准上市的技术产品仅为少数
市场上有关干细胞疗法的宣传众多,让人看花了眼。不禁要问,究竟哪些才是经过监管部门严格审核、有科学依据且安全有效的?
“通过欧美监管部门批准的干细胞疗法相对不多,约十几种,其中大部分是造血干细胞相关产品和技术,还有一些是对皮肤、软骨、眼角膜等部位损伤的治疗。”左为告诉记者,我国干细胞疗法还停留在临床试验阶段,目前还没有任何一种干细胞疗法真正通过国家相关部门的审批并上市销售。
经过多年发展,造血干细胞疗法日趋成熟,其原理是将他人或患者自己的造血干细胞注入到患者体内,重建骨髓造血及免疫功能。造血干细胞来源主要包括骨髓外周血和脐带血,可以用于治疗血液系统疾病,包括白血病、恶性淋巴瘤、骨髓增生异常综合征、多发性骨髓瘤等。
“目前市面上绝大多数通过审核批准的正规干细胞治疗产品都具有同一特点,即利用相应受损组织来源的干细胞来治疗疾病。”左为说,造血干细胞如此,其他类型干细胞产品亦如此。
例如,FDA批准的一项自体表皮移植术(Epicel)可用于被烧伤的成人和儿童患者,这类患者烧伤往往很严重,烧伤面积占全身表面积的30%以上。“该技术就是通过患者自身的表皮干细胞移植使患者再生出具有正常功能、较为完好的皮肤。”左为说。
再如,“2015年,干细胞产品Holoclar在欧盟获得有条件批准上市。目前Holoclar仅限于欧盟国家,还没有在其他国家上市。”左为表示。Holoclar通过患者自身眼角膜边缘处的干细胞来治疗成人患者因物理或化学灼烧而引起的中重度角膜缘干细胞缺陷症。此前欧盟相关监管部门证实该产品安全有效,但以防万一,其获得的上市批准是有条件的,制药公司要进行额外补充研究,并允许这款药物在欧洲上市。
“干细胞治疗领域虽有一些技术已经通过某些国家监管部门的认证或批准,但还是有很多技术仍在实验阶段。”左为告诉记者。
科学监管治理还需进一步完善
FDA代理局长内德·沙普利斯曾经说过,以细胞为基础的再生医学拥有重要的医学前景,但在未经批准的情况下使用可能给患者造成严重后果。
为了守好干细胞治疗领域的净土,很多国家都在探寻治理干细胞乱象的方法和策略。“欧盟国家和美国通常按照药品的规定来管理干细胞产品,而据我所知,日本和澳大利亚除了按照药品管理之外,还把干细胞技术做为一项医疗技术管理。”左为告诉记者,我国在过去很长一段时间内按照药品管理。直至2015年,原国家卫计委和原食药监总局联合发文,明确了干细胞临床研究的备案制度,我国也开始走向按照药品、技术管理的“*规双**制”道路。
按照药品管理和医疗技术管理有何不同?左为指出,对于药品来说,几乎所有满足基本条件的医疗机构都可以使用,即“多点”使用;而医疗技术则仅在某些特定的医疗机构有条件地应用,即“定点”使用。应用场景的不同注定了药品的生产、制备过程要比医疗技术更加严格,要求普适性、均一性。然而,正是由于药品对于质量要求远高于医疗技术,因此在干细胞药品的研究开发阶段,时间成本和经济成本也会高很多,需做大量的工艺优化、质量研究、稳定性研究并开展大样本临床实验等;而若以医疗技术的“规格”管理,干细胞技术可将应用者缩小至某家医院、某个团队甚至某位医师,有利于快速推进技术。
“干细胞治疗大规模应用还需时间,但干细胞治疗按药物管理是必然趋势。”国家干细胞工程技术研究中心主任韩忠朝曾在接受相关媒体采访时表示。左为也推测,未来干细胞治疗或将以药品管理的方法为主,辅之以医疗技术的方法进行管理。
“如何科学监管干细胞疗法,这是很多国家都需破解的难题,我国也在根据本国国情逐渐改革和构建较为完善的监管治理体系。”左为说。